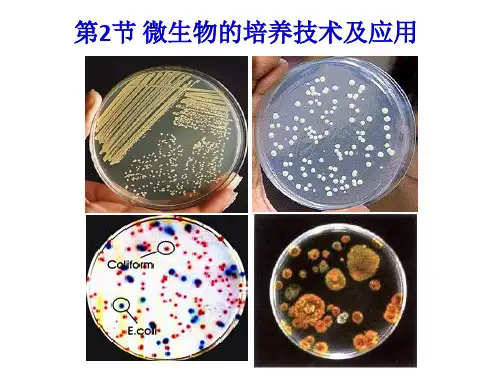

1.牛肉膏蛋白胨固体培养基配方
物质 牛肉膏 蛋白胨 NaCl 琼脂
重量 5g
10g 5g 20g
水
定溶至 1000mL
2、配制牛肉膏蛋白胨固体培养基的步骤
计算→称量→溶化→灭菌→倒平板
3、注意事项:
①倒平板的温度一般在50℃左右适宜 (温度过高会烫手,过低培养基又会凝固) ②平板需倒置 (这样既可使培养基表面的水分更好地挥发,又可防 止皿盖上的水珠落入培养基,造成污染)
特殊营养物质:如:生长因子(即细菌 生长必需,而自身不能合成 的化合物,如维生素、某些氨基酸、嘌 呤、嘧啶) pH:细菌pH为6.5–7.5; 放线菌pH
小结
培养基的营养物质及作用
营养物质
作用
举例
碳源
提供碳元素(有机碳源还能提供 无机碳源:CO2、NaHCO3
能量)
有机碳源:糖类、脂肪酸、
花生粉饼、石油
染的方法。 2、消毒:指使用较为温和 的物理或化学方法杀死物体 表面或内部的部分微生物 (不包括芽孢和孢子) 3、灭菌:使用强烈的理化 因素杀死物体内外所有的微 生物,包括芽孢和孢子。 4、归纳实验室常用的消毒
小结消毒
小结灭菌
1.无菌技术除了用来防止实验室的培养物 被其他外来微生物污染外,还有什么目的?
无菌技术还能有效避免操作者自身被微生物感染。
2.请你判断以下材料或用具是否需要消 毒或灭菌。如果需要,请选择合适的方法。
(1) 培养细菌用的培养基与培养皿 (2) 玻棒、试管、烧瓶和吸管 (3) 实验操作者的双手
(1)、(2)需要灭菌;(3)需要消毒。
3 .利用酒精消毒时,酒精浓度是不是越高越好?
氮源
提供氮元素,主要用于合成蛋白 分子态氮、氨、铵盐、硝酸 质、核酸以及含氮的代谢产物 盐、尿素、牛肉膏、蛋白胨